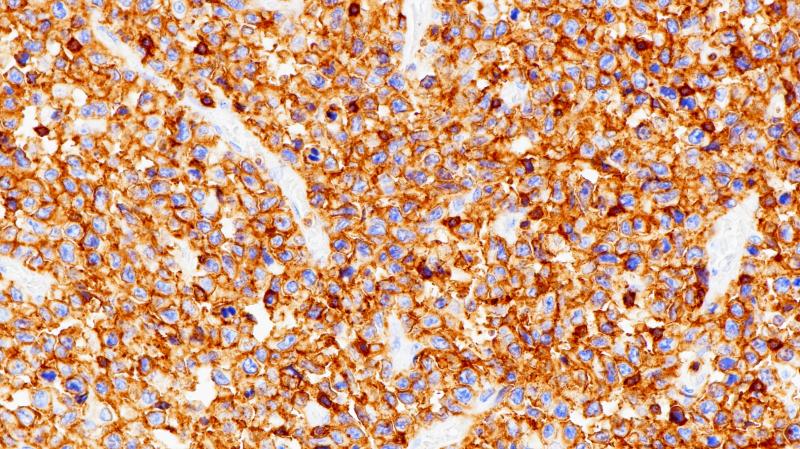
pd-l1 | 杭州百凌生物科技有限公司-官方网站

苏丹黑B染色

苏丹黑b染色液的应用和制备
图片尺寸254x303
b11000439 苏丹黑b|sundan blackb
图片尺寸1428x1364
苏丹黑b染色液 2×100ml 科研实验试剂 现货促销
图片尺寸1080x1080
苏丹黑b染色通常应用于组织化学中用于区分石蜡和动物脂肪,髓素染色
图片尺寸310x310
苏丹黑 b
图片尺寸640x1112![苏丹黑b,sudan black b;biological stain [生物染色剂]](https://i.ecywang.com/upload/1/img2.baidu.com/it/u=520152483,3987429076&fm=253&fmt=auto&app=138&f=PNG?w=640&h=212)
苏丹黑b,sudan black b;biological stain [生物染色剂]
图片尺寸640x212
苏丹黑b染色液(细胞专用)
图片尺寸647x647
苏丹Ⅲ染色液
图片尺寸850x850
苏丹iv酒精饱和溶液_胞内组分及亚结构染色液_染色液_染色试剂_索莱宝
图片尺寸850x850![苏丹黑b染色液 脂肪染色剂 实验 100ml/500ml [ph1230 phygene]](https://i.ecywang.com/upload/0/t13.baidu.com/it/u=349772992,2149034057&fm=224&app=112&f=JPEG?w=500&h=500)
苏丹黑b染色液 脂肪染色剂 实验 100ml/500ml [ph1230 phygene]
图片尺寸800x800
苏丹黑b_染色剂_染料_染色试剂_索莱宝-专业生化试剂网上商城
图片尺寸597x597
现货 苏丹黑b 4197-25-5 5g s8300 索莱宝solarbio 染色试剂
图片尺寸597x597
观察苏丹iii染色组织.
图片尺寸582x647
肝脂肪变性(苏丹iii染色)
图片尺寸640x508
pd-l1 | 杭州百凌生物科技有限公司-官方网站
图片尺寸800x449
苏丹黑b染色液 脂肪染色剂 实验室用科研实验试剂包邮现货速发
图片尺寸800x800
美国进口 实验试剂 脂类染色 苏丹黑b染色液 2x50ml
图片尺寸800x800
伊势久生物-现配试剂-实验用 配置溶液 试剂盒 苏丹黑b染色液
图片尺寸750x750
苏丹黑b/溶剂黑3 科研试剂 色素 高品质苏旦黑b cas:4197-25-5
图片尺寸4288x4288
苏丹黑b 溶剂黑3 脂肪黑hb 上海化学试剂 分析纯ar 生物染色剂bs
图片尺寸750x750





![苏丹黑b,sudan black b;biological stain [生物染色剂]](https://i.ecywang.com/upload/1/img2.baidu.com/it/u=520152483,3987429076&fm=253&fmt=auto&app=138&f=PNG?w=640&h=212)



![苏丹黑b染色液 脂肪染色剂 实验 100ml/500ml [ph1230 phygene]](https://i.ecywang.com/upload/0/t13.baidu.com/it/u=349772992,2149034057&fm=224&app=112&f=JPEG?w=500&h=500)












![苏丹黑b,sudan black b;biological stain [生物染色剂]](https://www.bszh.cn/images/thumbs/0001739_bsudan-black-bbiological-stain-.png)



![苏丹黑b染色液 脂肪染色剂 实验 100ml/500ml [ph1230 phygene]](https://img.alicdn.com/bao/uploaded/i1/66432062/O1CN01tBvvoQ1R6RNuQqEfn_!!66432062.jpg)